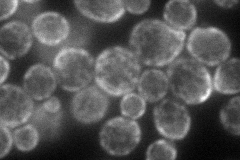
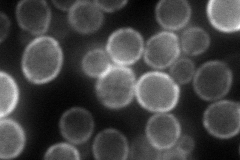
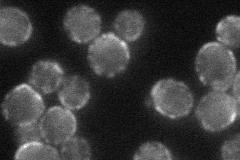
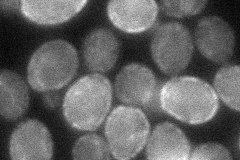
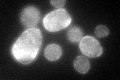
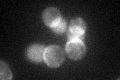
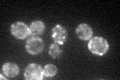

View description
Plasma membrane protein that may be involved in osmotolerance, localizes to the mother cell in small-budded cells and to the bud in medium- and large-budded cells; mRNA is transported to the bud tip by an actomyosin-driven process
Localization:
Intensity:
Fold change:
Significance:
-
C’ GFP library in SD

cell periphery46.84 -
N' NOP1pr-GFP in SD
cell periphery,punctate88.065 -
N' TEF2pr-mCherry in SD
cell periphery125.39 -
N' NATIVEpr-GFP in SD
cell periphery,punctate64.8035 -
N' TEF2pr-VC and Cyto-VN in SD
cell periphery40.9784 -
C’ GFP library in SD+DTT
cell periphery54.891.17No -
C’ GFP library in SD+H2O2
cell periphery40.030.85No -
C’ GFP library in Starvation Media
punctateN/AN/AYes -
C’ GFP library on the background of Pup2-DaMP

cell periphery -
C’ GFP library on the background of CCT mutant

cell periphery39.46280.84241No
